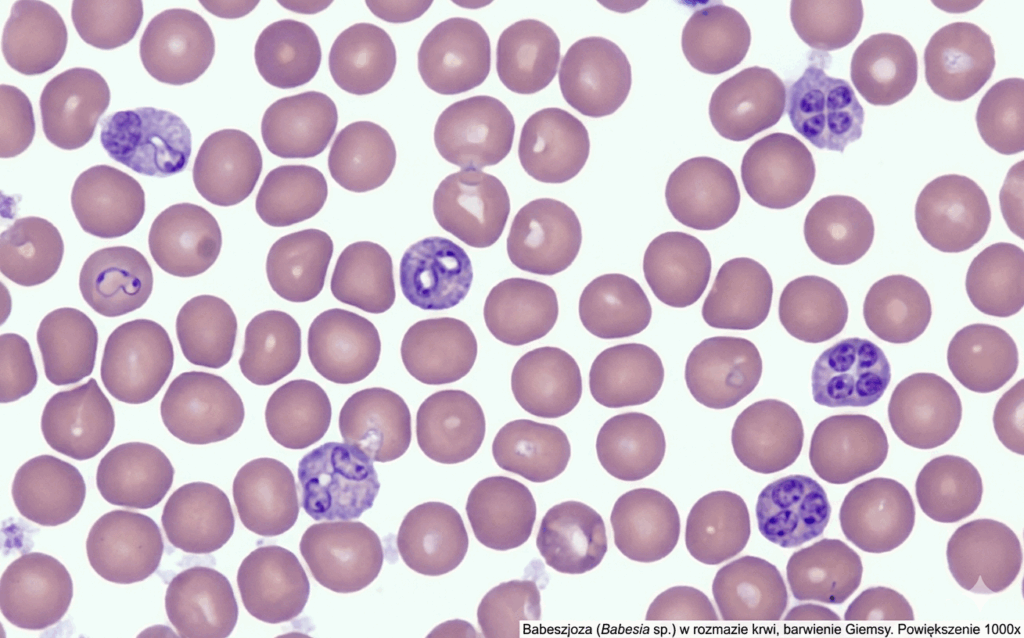

Profilaktyka przeciwkleszczowa u psa i choroby odkleszczowe – jak skutecznie chronić pupila?
Wraz z nadejściem cieplejszych dni, właściciele psów stają przed jednym z największych wyzwań współczesnej weterynarii – kleszczami. Te niewielkie pajęczaki nie są jedynie uciążliwymi pasożytami. To wektory groźnych patogenów, które mogą trwale uszkodzić zdrowie naszego pupila, a nawet doprowadzić do jego śmierci.
Współczesna profilaktyka nie powinna opierać się wyłącznie na chemicznych preparatach typu spot-on czy tabletkach. Fundamentem ochrony jest silny układ odpornościowy i odpowiednie wsparcie suplementacyjne, które zmienia “atrakcyjność” zwierzęcia dla pasożyta.
Najgroźniejsze choroby odkleszczowe – co musisz wiedzieć?
Choroby przenoszone przez kleszcze (VBD – Vector-Borne Diseases) stanowią jedno z najpoważniejszych zagrożeń dla zdrowia psów w naszej szerokości geograficznej. Kluczowym problemem jest fakt, że kleszcz podczas żerowania wprowadza do krwiobiegu żywiciela patogeny wraz ze swoją śliną, która zawiera substancje znieczulające i hamujące krzepliwość. Często infekcja ma charakter wielopatogenowy (koinfekcja), co drastycznie komplikuje diagnostykę i leczenie.
1. Babeszjoza (Piroplazmoza) – Cichy zabójca erytrocytów
Wywoływana przez pierwotniaka Babesia canis, jest najczęstszą i najbardziej gwałtowną chorobą odkleszczową w Polsce.
- Mechanizm: Pierwotniaki wnikają do czerwonych krwinek (erytrocytów), gdzie intensywnie się namnażają, doprowadzając do ich rozpadu.
- Objawy: Nagła wysoka gorączka (nawet do 41°C), skrajna apatia, blade lub pożółkłe błony śluzowe oraz charakterystyczny mocz o barwie ciemnego piwa (wynik hemoglobinurii).
- Zagrożenie: Nieleczona babeszjoza w ciągu 24-48 godzin prowadzi do ostrej niewydolności nerek i śmierci zwierzęcia.
2. Borelioza (Choroba z Lyme) – Podstępny stan zapalny
Wywoływana przez krętki Borrelia burgdorferi. U psów rzadko występuje rumień wędrujący, co czyni ją trudną do zauważenia w pierwszej fazie.
- Mechanizm: Bakterie migrują do tkanki łącznej, osiedlając się głównie w stawach, a niekiedy atakując układ nerwowy lub nerki (tzw. boreliozowe zapalenie nerek).
- Objawy: Nawracające, “wędrujące” kulawizny (pies kuleje raz na jedną, raz na drugą łapę), obrzęki stawów, niechęć do ruchu i tkliwość mięśniowa.
- Zagrożenie: Przejście w stan przewlekły może skutkować nieodwracalnymi zmianami w układzie ruchu i przewlekłą niewydolnością nerek.
3. Anaplazmoza granulocytarna – Atak na odporność
Wywoływana przez bakterie Anaplasma phagocytophilum, które atakują białe krwinki (granulocyty obojętnochłonne).
- Mechanizm: Bakteria upośledza funkcje obronne organizmu i zaburza procesy krzepnięcia krwi.
- Objawy: Gorączka, senność, bolesność stawów, ale także powiększenie węzłów chłonnych, śledziony oraz wybroczyny na dziąsłach czy krwawienia z nosa (wynik małopłytkowości).
- Zagrożenie: Często występuje jako koinfekcja z boreliozą, co potęguje wyniszczenie organizmu.
4. Ehrlichioza monocytarna – Niewidzialny wróg krwi

Sprawcą jest rickettsia Ehrlichia canis, atakująca monocyty i makrofagi.
- Mechanizm: Choroba przebiega w trzech fazach: ostrej, subklinicznej (może trwać lata bez objawów) i przewlekłej.
- Objawy: W fazie ostrej pojawia się gorączka i duszność. W fazie przewlekłej dochodzi do ciężkiego upośledzenia szpiku kostnego, co prowadzi do głębokiej pancytopenii (niedoboru wszystkich rodzajów komórek krwi).
- Zagrożenie: Jest szczególnie trudna do wykrycia w fazie utajonej, a jej faza przewlekła ma bardzo złe rokowania.
Proces transmisji większości tych patogenów trwa od 24 do 48 godzin od momentu wczepienia się kleszcza. Dlatego tak ważne jest stosowanie suplementacji wspomagającej, jak Charles V Cistus Stripes. Dzięki zawartości polifenoli, czystek nie tylko utrudnia kleszczowi podjęcie decyzji o wkłuciu (bariera zapachowa), ale też wspiera ogólną odporność immunologiczną, która jest kluczowa w walce z patogenami, zanim te zdominują organizm.
Diagnostyka – nie czekaj na “pełne objawy”
Jeśli znajdziesz na psie opitego kleszcza, a zachowanie zwierzęcia zmieni się choćby nieznacznie (np. pies odmówi jedzenia jednej porcji posiłku), natychmiast udaj się do lekarza weterynarii. Standardem w diagnostyce chorób odkleszczowych są obecnie szybkie testy diagnostyczne (np. typu SNAP 4Dx) oraz badanie morfologiczne krwi z oceną rozmazu manualnego pod mikroskopem.
Rola diety i suplementacji w profilaktyce
Skóra i jej zapach są pierwszą linią obrony. Kleszcze kierują się narządem Hallera, który wykrywa m.in. zapach potu, dwutlenek węgla i kwas masłowy. Zmieniając skład potu i zapach skóry poprzez suplementację, możemy sprawić, że pies stanie się dla kleszcza “nieatrakcyjny”.
Czystek (Cistus incanus) – Naturalna tarcza biologiczna

Jednym z najskuteczniejszych naturalnych wsparć w walce z pasożytami zewnętrznymi jest czystek. To roślina niezwykle bogata w polifenole – silne przeciwutleniacze, które odgrywają kluczową rolę w organizmie psa:
- Zmiana zapachu ciała: Regularne podawanie czystka wpływa na zmianę zapachu wydzielin skórnych. Dla człowieka jest to niewyczuwalne, jednak dla kleszczy staje się sygnałem odstraszającym.
- Wsparcie odporności: Wysoka zawartość polifenoli neutralizuje wolne rodniki, wzmacniając naturalne bariery obronne.
- Działanie przeciwzapalne: Czystek wspomaga regenerację tkanek po ewentualnym ukąszeniu.
Aby czystek zadziałał, musi być podawany regularnie przez minimum 4-6 tygodni, ponieważ jego substancje aktywne muszą “wysycić” organizm.
Rekomendacja ekspercka: Charles V Cistus Stripes
Wybierając suplement, należy zwrócić uwagę na jego jakość, czystość surowca oraz formę podania. Produktem, który doskonale wpisuje się w założenia profilaktyki zootechnicznej, są Charles V Cistus Stripes.
Dlaczego warto wybrać ten produkt?
- Wysoka biodostępność: Forma pasków (stripes) jest nie tylko atrakcyjna smakowo dla psa, ale przede wszystkim ułatwia precyzyjne dawkowanie i regularność, która w przypadku czystka jest kluczowa.
- Czystość składu: Produkt bazuje na wysokiej jakości surowcach roślinnych, bez zbędnych wypełniaczy, które mogłyby obciążać układ pokarmowy psa.
- Wsparcie wielokierunkowe: Poza ochroną przed kleszczami, zawarty w produkcie czystek działa detoksykująco i wspiera higienę jamy ustnej.
- Bezpieczeństwo: W przeciwieństwie do agresywnej chemii, czystek nie obciąża wątroby i nerek, co czyni go idealnym wyborem dla psów wrażliwych, starszych oraz jako uzupełnienie standardowej ochrony.
Jak zbudować skuteczny plan ochrony?
Skuteczna walka z kleszczami to tzw. metoda kombinowana:
- Krok 1: Ochrona weterynaryjna Zastosuj obrożę, tabletkę lub krople (konsultując wybór z lekarzem weterynarii).
- Krok 2: Suplementacja “od środka”. Wprowadź do diety czystek, np. w formie wygodnych pasków Charles V Cistus Stripes, aby stworzyć barierę zapachową.
- Krok 3: Przegląd po spacerze. Żaden preparat nie zastąpi mechanicznego sprawdzenia skóry psa po powrocie z lasu czy łąki.
- Krok 4: Dbaj o mikrobiom. Zdrowe jelita to silna odporność, która pomaga psu walczyć z patogenami, jeśli dojdzie do zakażenia.
Podsumowanie
Choroby odkleszczowe to realne zagrożenie, którego nie wolno bagatelizować. Jednak jako świadomi opiekunowie, nie musimy polegać wyłącznie na syntetycznych rozwiązaniach. Połączenie nowoczesnej medycyny weterynaryjnej z naturalnym wsparciem zootechnicznym, takim jak suplementacja czystkiem, pozwala stworzyć najszczelniejszą tarczę ochronną dla naszego psa.
Inwestycja w profilaktykę, w tym w wysokiej jakości przysmaki funkcjonalne, to nie tylko oszczędność na kosztownym leczeniu babeszjozy, ale przede wszystkim zapewnienie naszemu czworonogowi komfortu i zdrowia przez cały sezon.
Artykuł napisany we współpracy z marką 77 Seven Seven
Bibliografia
Centers for Disease Control and Prevention (CDC)
3. How to Prevent Mosquito and Tick Bites
4. Prevent Tickborne Diseases in People and Pets (PDF)
5. Prevent Tickborne Diseases in People (CDC Stacks)
7. Thics
9. Diseases Spread by Ticks | Travelers’ Health
10. Pet ownership increases human risk of encountering ticks (PDF)
ESCCAP
11. GL5: Control of Vector-Borne Diseases in Dogs and Cats
12. GL5: Control of Vector-Borne Diseases in Dogs and Cats (PDF)
13. GL3: Control of Ectoparasites in Dogs and Cats
14.) GL3: Control of Ectoparasites in Dogs and Cats (PDF
15. https://www.esccap.org/page/GL3MG3%2BControl%2Bof%2BEctoparasites%2Bin%2BDogs%2Band%2BCats/43/
16. GL5: Control of Vector-Borne Diseases in Dogs and Cats (page archive / document listing
17. GL3: Control of Ectoparasites in Dogs and Cats (page archive / document listing)
20. Documents
22. Guideline Maps